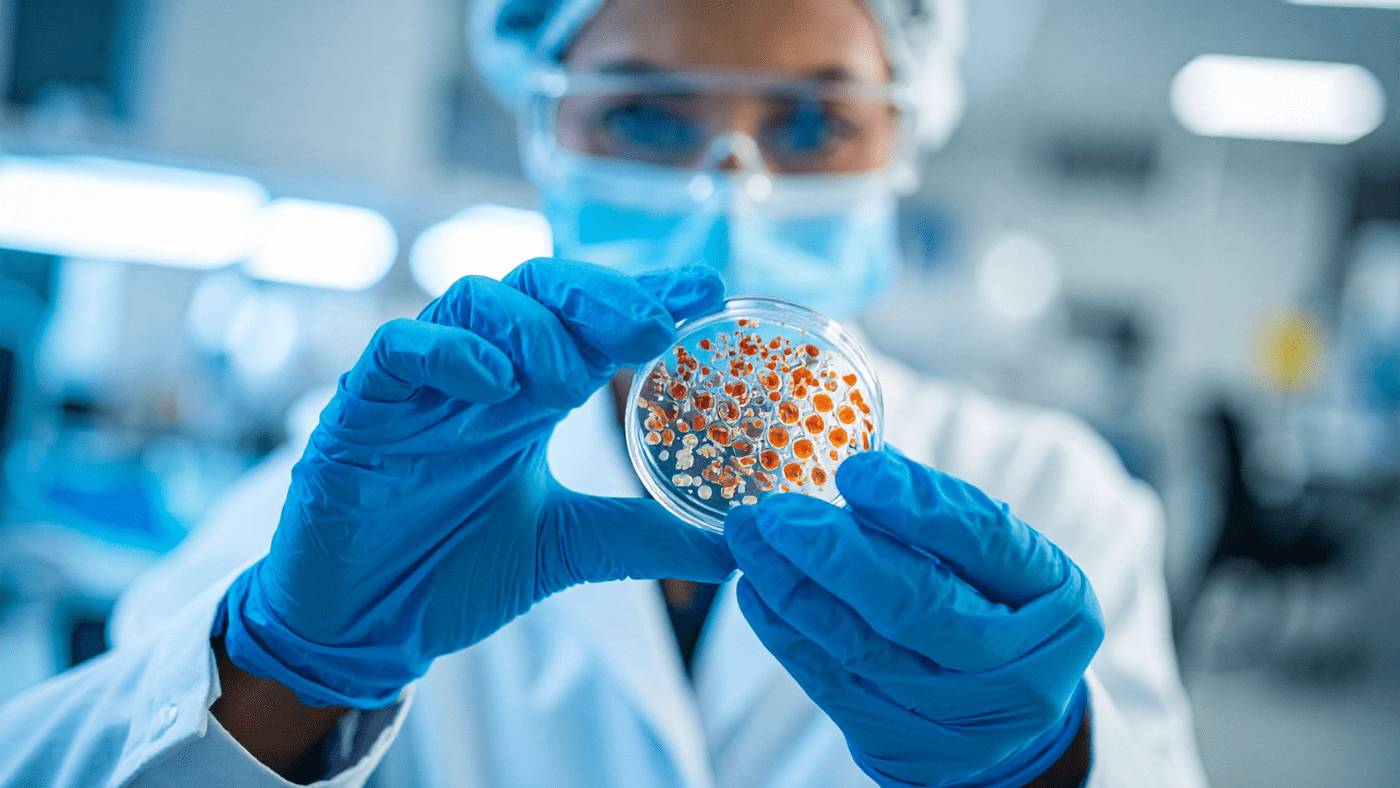

Work on Next-Generation CAR-T Therapies with QbD Group
We’re expanding our team to support one of the most innovative CAR-T cell therapy projects in life sciences. This is your opportunity to contribute to breakthrough treatments, work alongside industry experts, and grow your career in a fast-moving, high-impact environment.
At QbD Group, you don’t just join a project, you join a community of professionals committed to innovation, collaboration, and sustainable career development.

Why join this project?
Be part of life-changing innovation
Contribute to next-generation CAR-T therapies that are shaping the future of medicine and transforming patient outcomes.
Work alongside experts in advanced therapies
Collaborate with multidisciplinary teams at the forefront of biotech innovation. Learn from experienced specialists and expand your expertise in cutting-edge technology.
Build a sustainable career with QbD Group
You stay in the driver’s seat of your career — exploring multiple projects, learning continuously, and shaping your long-term path within QbD Group.
Join a strong QbD project team
You’ll work within a supportive, high-performing QbD Group team where meaningful connections, mentorship, and collaboration are central to daily work.
“Projects in advanced therapies push you to think differently and innovate every day. What I value most is how QbD Group supports its people — you’re trusted with responsibility, but you’re never on your own. The sense of community here is a real strength.”
- Jeroen Verschueren, Project Manager
Think you’re a fit? Here’s who we’re looking for
We’re looking for motivated life sciences professionals with 1 to 5 years of experience in:
- Advanced therapies / CAR-T
- Biotech, pharma, or cell & gene therapy
- GMP, QA, validation, manufacturing, or engineering
- Qualification & Validation, GMP, facilities & utilities, process equipment, isolators, temperature controlled equipment
If you bring curiosity, ambition, and a passion for innovation, we’d love to connect!
Ideal candidates are based in East or West Flanders though we’re happy to have conversations with other experienced professionals in the region.



